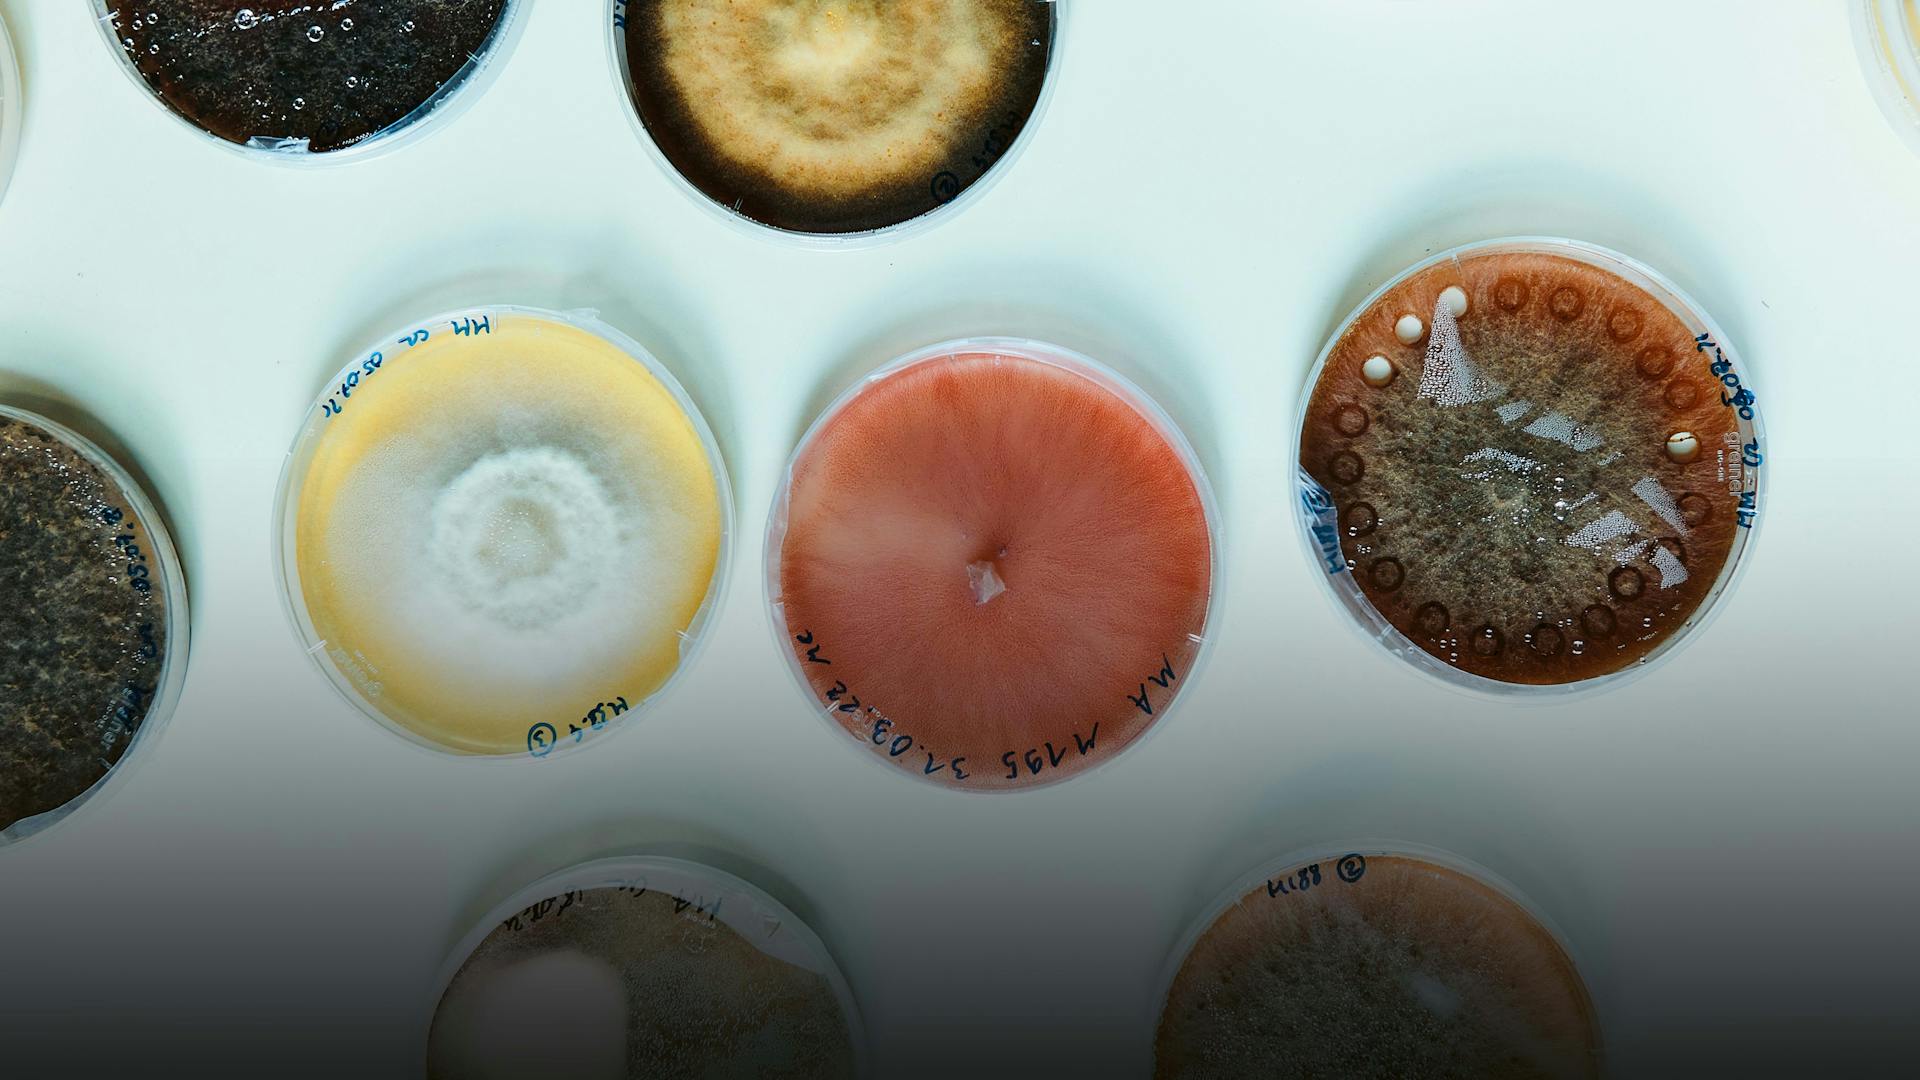
content-image

A mushroom model at the University of Neuchâtel.
Published on 03/10/2022
It is the fungal models that first catch our eye as we walk with Pilar Junier in the research wing of the Microbiology Lab at the University of Neuchâtel. On this sunny spring morning, about a dozen of these wondrous specimens stand in the window niches of the modern building high above Lake Neuchâtel, which offer a spectacular view of the Alps.
Poisonous and edible species are clearly labeled, and we quickly realize the danger behind the seemingly harmless common potato puffball and the fiery toadstool.
Even though the diverse colors and shapes of the mushrooms appear quite exotic on the bare concrete of the window niches, they are ubiquitous in nature and thus an obvious and central object for Junier and her 30-member laboratory and research team.
In the labs, the professor also shows us the numerous Petri dishes and analytical equipment used to study the interaction of fungi and other microbial partners within the environment. The doors are usually open, and the hustle and bustle of the graduate and Ph.D. students in the corridors and laboratories seems like a microcosm of its own within the university, intensely and very intently dedicated to a mysterious task.
This microcosm clearly revolves around 44-year-old Pilar Junier: A quick glance into one of her 12 research labs is enough for her to give the people working in there the necessary instructions in exactly the language they understand best – French, English, German or even in Spanish, her mother tongue.
Professor and more
Pilar Junier was born in Colombia, where she also studied. The country lies on the Pacific Ring of Fire, and six of the country’s ten volcanoes are still considered active. Junier obviously brought some of this energy from her homeland, because it would otherwise be hard to explain how she is able to reconcile her diverse tasks.
As a professor, she heads the laboratory of microbiology at the University of Neuchâtel, where she also lectures, mentors Ph.D. and Master’s students and trains biology lab technicians. In addition, she develops new projects and ideas and raises funds to keep the labs running. Then, if there is still time, she works on turning the dream of owning her own company into a reality.
With the Novartis Foundation’s FreeNovation project, launched in 2016 to promote innovative ideas in medicine, Junier was able to complete several items on her to-do list. But how does an environmental microbiologist who has never been involved in medicine in her career get a grant from a medical foundation?
A crazy idea
To apply for FreeNovation, Junier did not have to submit any patient- related data that supported her idea. Nor would that have been possible at the time, she tells us candidly. Another positive aspect was that the decision in the selection process was made by a jury who quite deliberately was not given any insight into Junier’s CV, but only had to judge the quality of the submitted idea. “That is why they also allowed an environmental microbiologist to do a medical project. It’s not like I had a background in pulmonology or anything. But I just had this crazy idea to work with people,” Junier recalls.
The “crazy idea” did not come to Pilar Junier and her team in a dream, however, but because of their many years of research in environmental microbiology. Junier, along with a postdoctoral researcher and a doctoral student, Fabio Palmieri, 30, and Aislinn Estoppey, 29, had already conducted numerous projects with soil samples. Their main interest was the interaction between oxalic acid, fungi and bacteria – a traditional approach in the field of environmental microbiology that is also being studied, for example, to improve soil fertility or to store CO2 in the soil.
“The basic question in our FreeNovation application was: Why do we not look at people as if we were looking at our soil samples, as something that is just a bit more complex than human cells?” says Junier, and immediately provides a concrete task to go with it: “Every year, around 1.5 million people die from fungal diseases, and current treatment methods are very limited. That is why we wanted to use the knowledge we have gained about fungi over the years and investigate whether and how we could use it as a therapeutic alternative to control pathogenic fungi in human medicine.”
Two sides of the same substance
In their previous experiments, Junier and her team had found that oxalic acid is a critical environmental factor in the interaction of two fundamental elements of the human microbiome: bacteria and fungi. In environmental microbiology, for example, the secretion of oxalic acid by fungi is not only common, but even essential for their survival.
In humans, however, the salts of oxalic acid in particular, such as calcium oxalate, can cause health problems. Crystals of calcium oxalate have also been found in the lungs of immunocompromised patients suffering from mold infections. However, inhaling fungal spores alone is not a cause for concern, as Junier explains. “Everyone breathes in thousands of spores every day, but in healthy individuals, this does not trigger any problems. In immunocompromised patients, on the other hand, this can lead to colonization of the lung tissue with spores and eventually to fungal infections.”
On this basis, Junier and her team formulated their hypothesis for the FreeNovation project, which states that fungi also produce oxalic acid in human lungs to create an optimal environment for their further development.